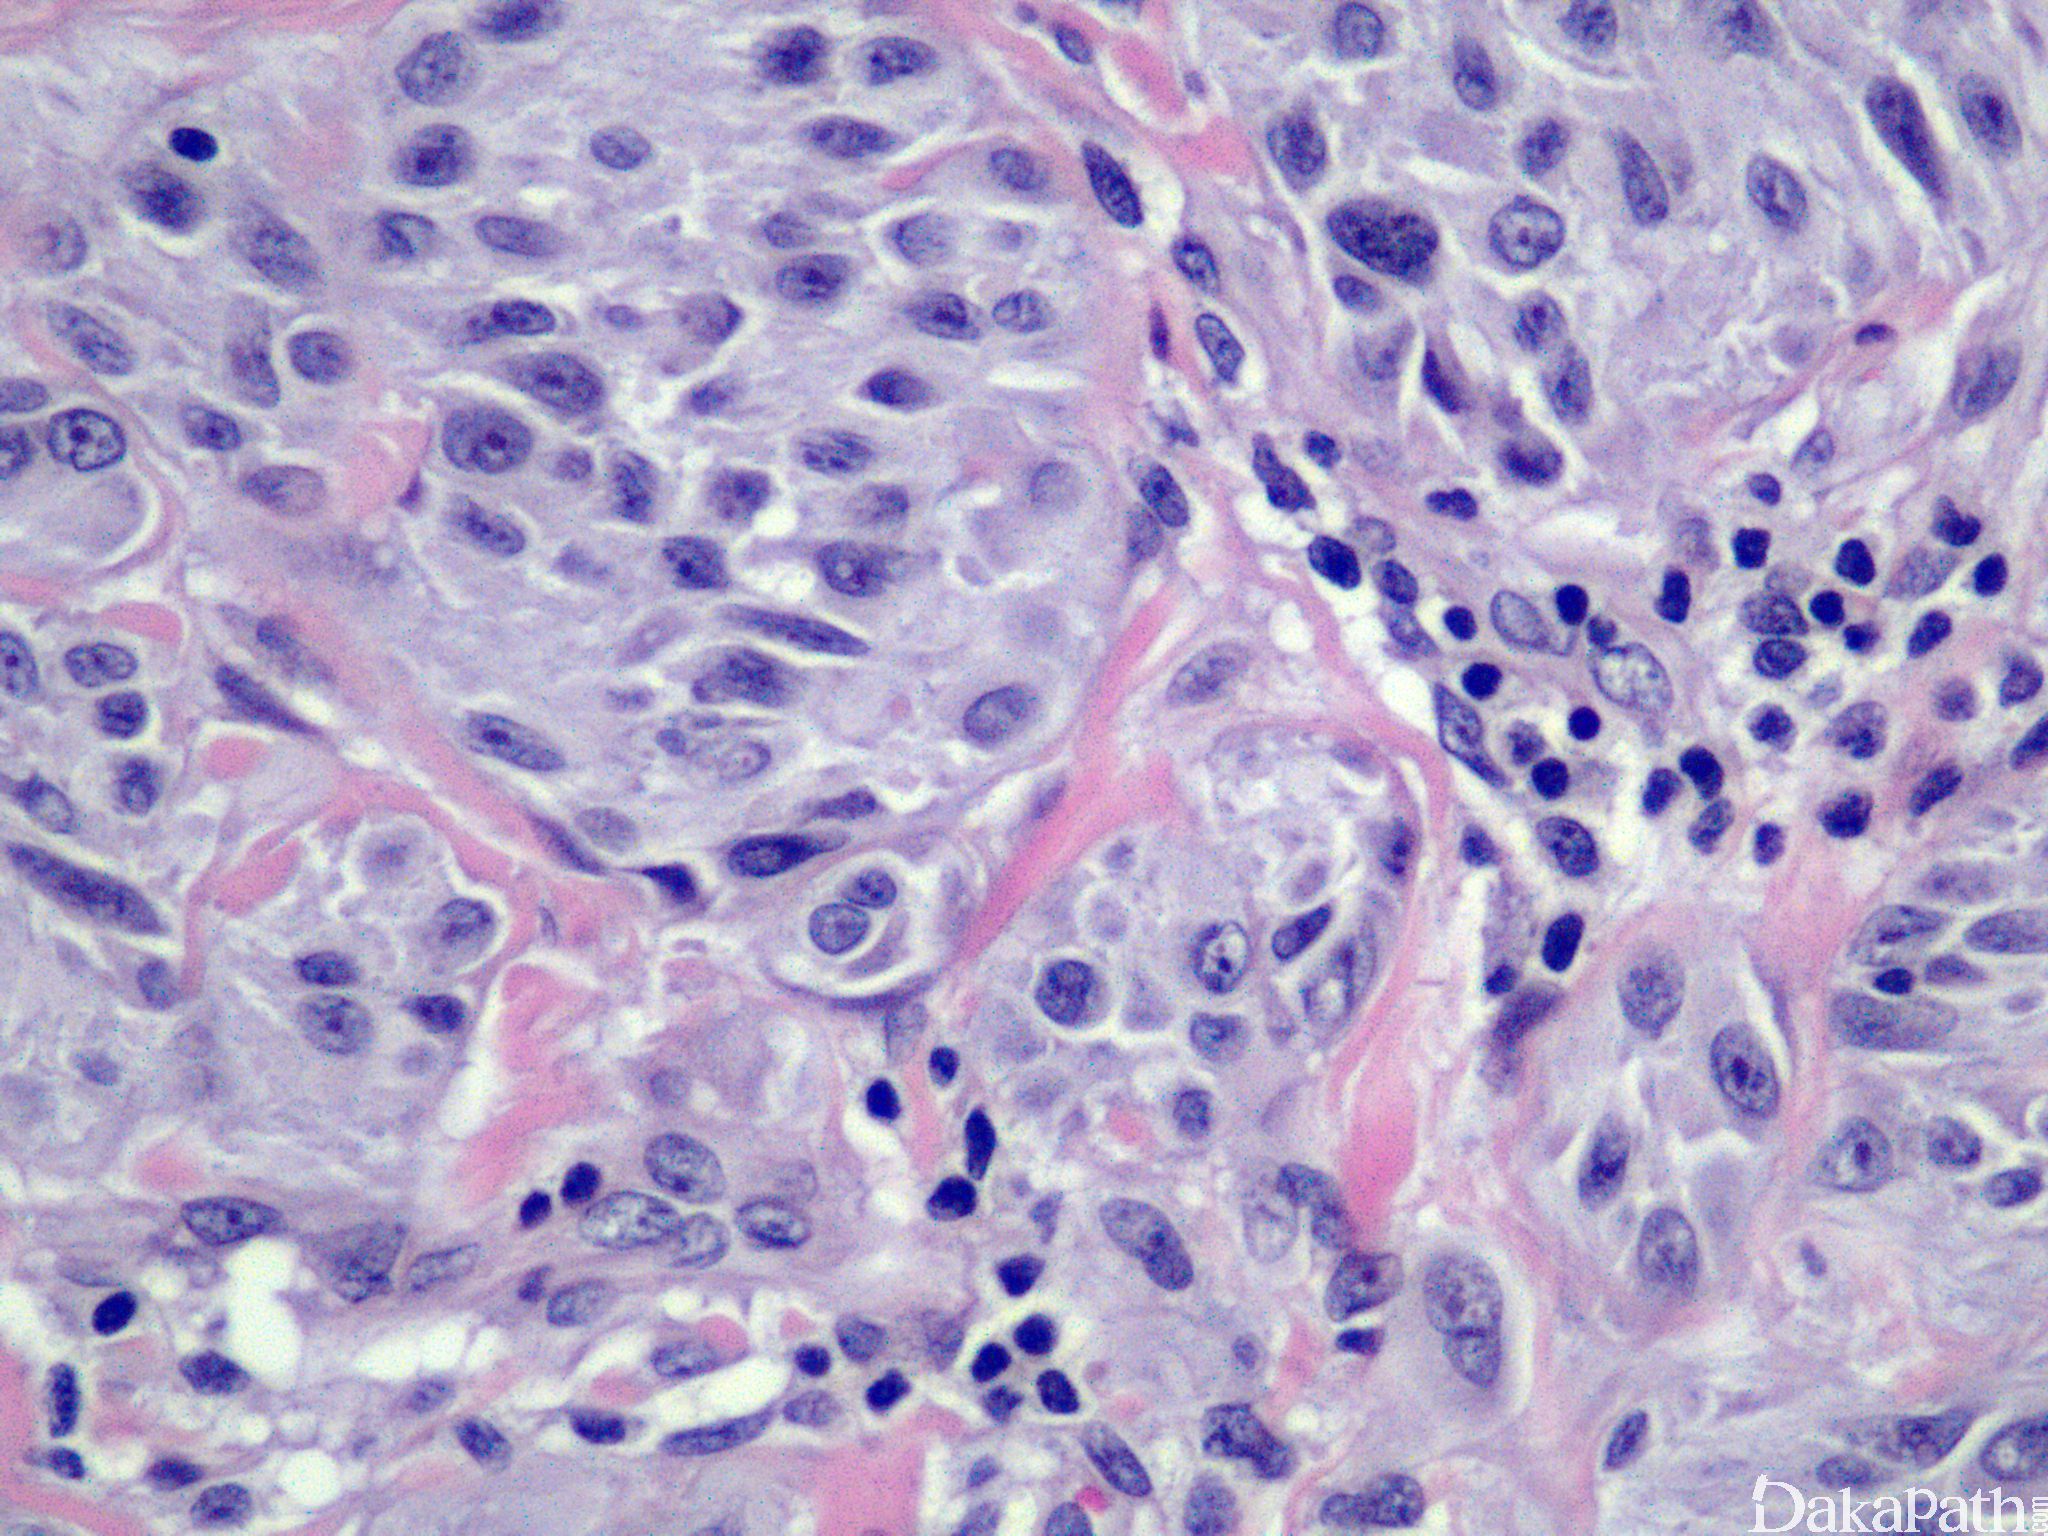

不典型 Spitz 痣
Atypical Spitz Nevus
诊断要点:
主要见于年轻病人;
交界性或复合型 Spitz 痣具有以下下特征之一,但不能满足恶性黑色素瘤的诊断标准者,可诊断为不典型 Spitz 痣:
不对称;
单个细胞为主(4mm 以上细胞巢较少);
溃疡;
真皮大片黑色素细胞;
真皮内成分无成熟表现;
深部可见核分裂像;
广泛累及皮下;
核多形性。
免疫组织化学染色:
S100. HMB45 仅在表皮-真皮交界或表浅部分阳性,melan-A 阳性;无 N-RAS、B-RAF 基因突变。
← 促结缔组织增生型Spitz痣 Spitz痣 →